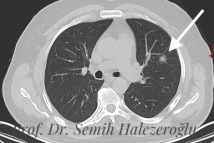
Akciğer kanseri teşhis ve tedavisi {{brizy_dc_image_alt imageSrc=

Prof. Dr. Semih Halezeroğlu
Acıbadem Üniversitesi Tıp Fakültesi
Göğüs Cerrahisi Anabilim Dalı Başkanı
Zamanla Yarışırken Doğru Bilgiye Uzaktan Ulaşın.
Türkiye'de kapalı akciğer ameliyatlarının öncüsü Prof. Dr. Semih Halezeroğlu'ndan dünyanın neresinde olursanız olun Online İkinci Görüş alın.

Göğüs Cerrahisinde 30 Yıllık Akademik ve Klinik Otorite
- Öncülük: Türkiye’deki ilk kapalı akciğer ameliyatı (1992) ve ilk Tek Port VATS (2009) uygulamaları.
- Küresel Liderlik: Avrupa Göğüs Cerrahları Derneği (ESTS) Başkanı seçilen ilk Türk cerrah.
- Deneyim: 3.000’den fazla başarılı Uniportal VATS operasyonu ile dünya literatürüne katkı.
- Eğitim: 16 yıl boyunca Acıbadem Üniversitesi Göğüs Cerrahisi Anabilim Dalı Başkanlığı.